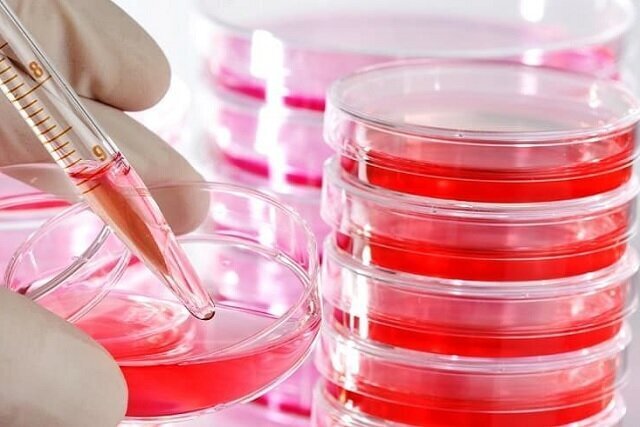
برگزاری کارگاه سه‌روزه کشت سلول

کارگاه کشت سلول، با همکاری مرکز تحقیقات پروتئین دانشگاه شهید بهشتی و پژوهشگاه ابنسینا برگزار میشود.

به گزارش
خبرگزاری صدا و سیما، کارگاه کشت سلول در روزهای شنبه تا دوشنبه ۶ تا ۸ خردادماه ۱۴۰۲ در محل پژوهشکده پروتئین دانشگاه شهید بهشتی برگزار میشود.
محورهای اصلی این کارگاه در 3 روز فعالیت خود شامل، طراحی آزمایشگاه کشت سلول و معرفی تجهیزات؛ استریلیزاسیون، اصول GLP و تکنیک آسپتیک در آزمایشگاه کشت سلول؛ اصول و مبانی کشت سلول؛ محلولسازی، تهیه و کنترل کیفی محیطهای کشت سلول؛ ذوب (Thaw) و انجماد (Freeze) سلول؛ کشت سلولهای سوسپانسیون و چسبنده؛ شمارش سلول و تعیین Viability؛ پاساژدهی، تک کلونگیری و تهیه رقتهای سریال سلولی؛ تشخیص، درمان و پیشگیری انواع آلودگیهای سلولی؛ معرفی بانکهای سلولی جهانی و آشنایی با انواع ردههای سلولی؛ اصول کلی سمیت و مرگ سلولی است.
علاقهمندان برای کسب اطلاعات بیشتر و ثبتنام در این کارگاه میتوانند با شماره تلفن ۲۲۴۳۲۰۲۰ داخلی ۴۵۹ یا شماره ۲۲۴۳۱۹۴۵ تماس حاصل نمایند.
منبع خبر "
صدا و سیما" است و موتور جستجوگر خبر تیترآنلاین در قبال محتوای آن هیچ مسئولیتی ندارد.
(ادامه)
با استناد به ماده ۷۴ قانون تجارت الکترونیک مصوب ۱۳۸۲/۱۰/۱۷ مجلس شورای اسلامی و با عنایت به اینکه سایت تیترآنلاین مصداق بستر مبادلات الکترونیکی متنی، صوتی و تصویری است، مسئولیت نقض حقوق تصریح شده مولفان از قبیل تکثیر، اجرا و توزیع و یا هرگونه محتوای خلاف قوانین کشور ایران بر عهده منبع خبر و کاربران است.
به گزارش خبرگزاری صدا و سیما، کارگاه کشت سلول در روزهای شنبه تا دوشنبه ۶ تا ۸ خردادماه ۱۴۰۲ در محل پژوهشکده پروتئین دانشگاه شهید بهشتی برگزار میشود.
به گزارش خبرگزاری صدا و سیما، کارگاه کشت سلول در روزهای شنبه تا دوشنبه ۶ تا ۸ خردادماه ۱۴۰۲ در محل پژوهشکده پروتئین دانشگاه شهید بهشتی برگزار میشود.